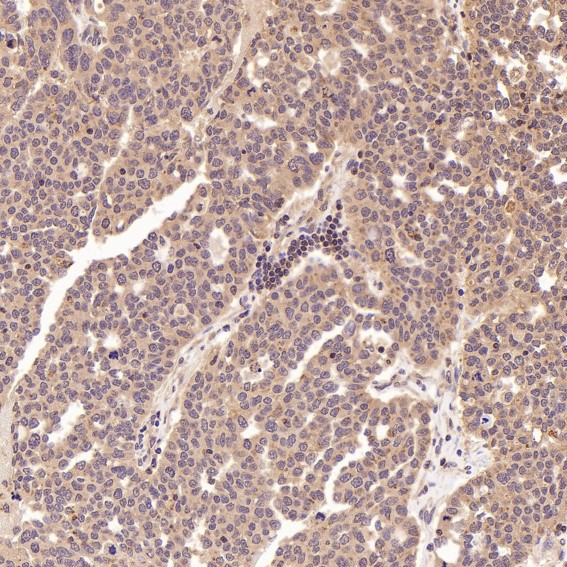
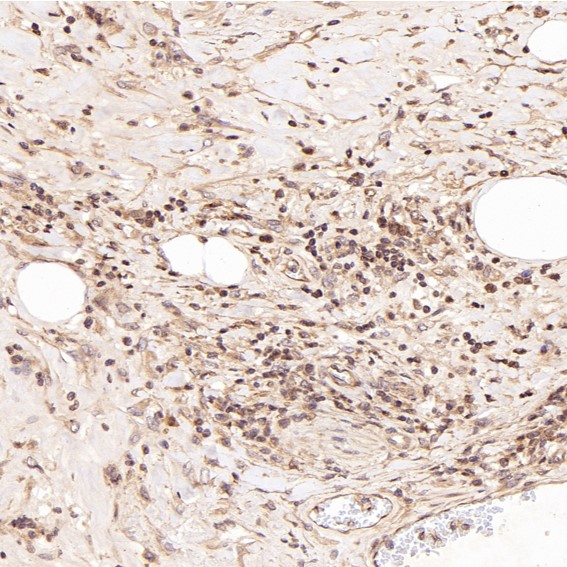

单克隆抗体
MMP11 Antibody (CY5778)
UniProt:P24347
Application:WB,IHC,ICC/IF
Reactivity:Human,Mouse,Rat
Source:Rabbit mAb
MMP11 Antibody (CY5778)
UniProt:P24347
Application:WB,IHC,ICC/IF
Reactivity:Human,Mouse,Rat
Source:Rabbit mAb
http://www.abways.cn/showproduct.asp?cid=CY5778
IRF3 Antibody (CY5779)
References (1)
UniProt:Q14653
Application:WB,IHC,ICC/IF,FC
Reactivity:Human,Mouse,Rat
Source:Rabbit mAb
IRF3 Antibody (CY5779)
UniProt:Q14653
Application:WB,IHC,ICC/IF,FC
Reactivity:Human,Mouse,Rat
Source:Rabbit mAb
References(1)
http://www.abways.cn/showproduct.asp?cid=CY5779
Caspase-2 Antibody (CY5780)
UniProt:P42575
Application:WB
Reactivity:Human,Mouse,Rat
Source:Rabbit mAb
Caspase-2 Antibody (CY5780)
UniProt:P42575
Application:WB
Reactivity:Human,Mouse,Rat
Source:Rabbit mAb
http://www.abways.cn/showproduct.asp?cid=CY5780
Oct4 Antibody (CY5781)
References (2)
UniProt:Q01860
Application:WB,IHC,ICC/IF,IP,ChIP
Reactivity:Human,Mouse
Source:Rabbit mAb
Oct4 Antibody (CY5781)
UniProt:Q01860
Application:WB,IHC,ICC/IF,IP,ChIP
Reactivity:Human,Mouse
Source:Rabbit mAb
References(2)
http://www.abways.cn/showproduct.asp?cid=CY5781
Caspase-9 Antibody (CY5782)
UniProt:P55211
Application:WB,IHC,ICC/IF,IP
Reactivity:Human,Mouse
Source:Rabbit mAb
Caspase-9 Antibody (CY5782)
UniProt:P55211
Application:WB,IHC,ICC/IF,IP
Reactivity:Human,Mouse
Source:Rabbit mAb
http://www.abways.cn/showproduct.asp?cid=CY5782

销售咨询
销售咨询 一键电话
一键电话